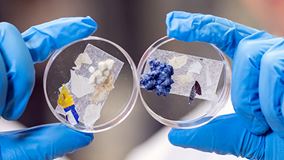

Rising soil nitrous acid emissions driven by climate change and fertilisation

Sharp depletion in soil moisture drives land water to flow into the oceans
Hidden microbial threats to ecosystem caused by plastic waste

PolyU develops low-carbon marine self-healing concrete to achieve carbon neutrality

PolyU develops low-carbon marine self-healing concrete to achieve carbon neutrality

Disparities in pollution exposure and advocating for targeted mitigation measures

Critical role of humidity and indoor conditions in heatwave severity assessments

Geotechnical Resilience through Intelligent Design

Novel carbon dots-driven green radiative cooling coating for energy saving in buildings

Reveal effectiveness of GBGI infrastructure in mitigating urban heat

GeoAI technologies in earth observation to tackle environmental challenges

Food Waste-derived 3D Printing Material

Biomineralization as a sustainable strategy against microbial corrosion in marine concrete

Recycling textile waste as thermal insulations for multi-functional building clothing

Nature-inspired advanced materials to achieve 99.6% solar reflectivity

Strong and ductile titanium-oxygen-iron alloys by additive manufacturing

Harnessing materials and mechanics science for a sustainable energy

Efficient and Scalable Moisture-Electric Generators Made From Ionic Hydrogel

Low-carbon transformation of construction materials using waste glass

Development of nanotechnology based hybrid air cleaning system towards green transport